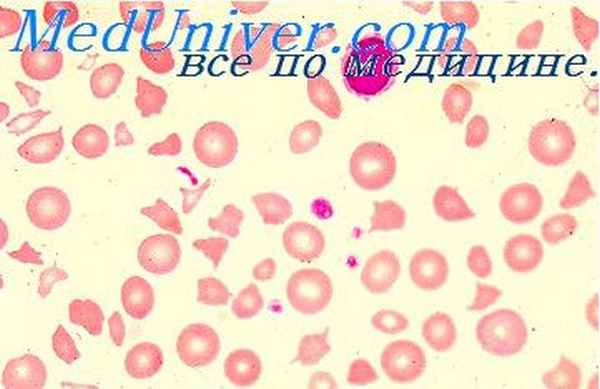

Синдром Жильбера— Леребулле - семейная гипербилирубинемия. Синдром Криглера — Найяра и Люцея — Ариаса — Дрисколла
Добавил пользователь Евгений Кузнецов Обновлено: 13.12.2025
Синдром Криглера-Найяра характеризуется:
- крайне высоким содержанием в крови непрямого (несвязанного) билирубина;
- отсутствием или снижением активности глюкуронилтрансферазы, переводящей свободный билирубин в связанный.
Впервые это нарушение обмена билирубина было описано в 1952 году у новорождённых американскими педиатрами Crigler John Fielding, Jr. (Кри'глер Джон, младший) и Najjar Victor Assad (На'йяр).
Различают две генетически гетерогенные формы синдрома:
- Синдром Криглера-Найяра I типа встречается очень редко, имеет аутосомно-рецессивный тип наследования. Гипербилирубинемия обусловлена полным отсутствием глюкуронилтрансферазы вследствие генетического дефекта. Непрямой билирубин превышает норму в 15-50 раз. Непрямой билирубин является нейротропным ядом: повышенный уровень билирубина вызывает повреждение центральной нервной системы (базальные и стволовые ядра головного мозга) и может приводить к развитию билирубиновой энцефалопатии (ядерной желтухи). Уровень непрямого билирубина, при котором возникает угроза энцефалопатии — 340 мкмоль/л. Прогноз неблагоприятный, больные обычно погибают в младенчестве (ребёнок редко доживает до 1,5 лет).
- Синдром Криглера-Найяра II типа встречается редко, имеет аутосомно-доминантный тип наследования. Активность глюкуронилтрансферазы резко снижена, непрямой билирубин превышает норму в 5–20 раз. Для индукции микросомальной активности фермента можно применять фенобарбитал. Больные доживают до среднего возраста (36-44 года) и более. В отдалённом периоде могут встречаться глухота, хореатетоз и другие неврологические повреждения, но в большинстве случаев клинические последствия отсутствуют.
Дифференциальный диагноз
Синдром Криглера-Найяра необходимо отличать от следующих состояний:
- Физиологическая желтуха новорождённых и желтуха недоношенных детей. Причина — физиологическая незрелость ферментных систем печени. Желтуха наблюдается у 50% доношенных и более чем у 80% недоношенных новорождённых. Желтуха развивается на 2-3 день жизни и проходит в течение 7-10 дней без какого-либо вмешательства. Уровень непрямого билирубина обычно не превышает норму в 5-10 раз и не сопровождается симптомами повреждения ЦНС (мышечная гипертония, нистагм, атетоз, судороги). У недоношенных уровень билирубина обычно выше, а желтуха сохраняется дольше (до 14-15 дня жизни).
- Синдром Люси-Дрисколла (Lucey-Driscoll). В отечественной литературе часто пишут, как синдром Люцея-Дрисколла. Это транзиторная семейная гипербилирубинемия новорождённых, связанная с присутствием в у некоторых женщин в грудном молоке ингибиторов конъюгации билирубина (производные прегнандиола). Желтуха обычно исчезает через несколько дней после прекращения грудного вскармливания.
- Гемолитические желтухи новорождённых обусловлены гемолизом различного генеза (резус-конфликт, врождённые аномалии гемоглобина или эритроцитов).
Лечение
Общие рекомендации — см. синдром Жильбера. Фенобарбитал увеличивает содержание глюкуронилтрансферазы, поэтому его приём уместен в период обострения синдрома Криглера-Найяра II типа в дозе 30-200 мг/сут. в течение 2-4 недель.
Синдром Дубина-Джонсона
В 1954 году американцы Dubin I. Nathan (Ду'бин) и Johnson F. (Джо'нсон) описали доброкачественную желтуху с повышением прямой фракции билирубина.
Синдром Дубина-Джонсона (в отечественной литературе часто обозначается, как синдром Дабина-Джонсона) характеризуется:
- умеренным повышением в крови прямого (связанного) билирубина вследствие нарушения механизмов его транспорта из гепатоцитов в желчь;
- повышенным выделением с мочой желчных пигментов;
- отложением в гепатоцитах тёмно-коричневого или буро-оранжевого липохромного пигмента (устанавливается при пункционной биопсии печени);
- аутосомно-рецессивным типом наследования.
Синдром Дубина-Джонсона распространён среди иранских евреев в ассоциации с недостаточностью VII фактора свертывания крови.
Симптоматика более ярко выражена, чем при других формах гипербилирубинемии. Пациенты жалуются на повышенную утомляемость, плохой аппетит, боль в правом подреберье. Печень при синдроме Дубина-Джонсона не может адекватно экскретировать билирубин и контрастные препараты, используемые для холецистографии, поэтому частой находкой является отсутствие тени желчного пузыря при холецистографии.
Выраженность желтухи может варьировать, усиливаясь на фоне инфекционных заболеваний, при приёме оральных контрацептивов и беременности. Во время ремиссии желтуха почти полностью исчезает. Зачастую синдром Дубина-Джонсона не замечают до наступления беременности или приёма оральных контрацептивов.
Прогноз благоприятный. Медикаментозного лечения не существует, хотя в определённой степени повышенный уровень билирубина поддаётся коррекции фенобарбитолом. Общие рекомендации — см. синдром Жильбера.
Синдром Ротора
В 1948 году филиппинский терапевт Rotor Arturo B. (Ро'тор) описал вариант доброкачественной желтухи с повышением прямой фракции билирубина, но с нормальной морфологической картиной печени. Подобное состояние получило название синдром Ротора, хотя некоторые считали его лишь вариантом синдрома Дубина-Джонсона.
Синдром Ротора очень редкое состояние, первичный биохимический дефект в отличие от других функциональных гипербилирубинемий не идентифицирован.
Синдром Ротора характеризуется:
- умеренным повышением в крови прямого (связанного) билирубина вследствие нарушения механизмов его транспорта из микросом гепатоцитов в желчь,
- повышенным выделением с мочой желчных пигментов,
- отсутствием тёмно-коричневого пигмента в гепатоцитах при пункционной биопсии и визуализацией желчного пузыря при холецистографии,
- аутосомно-рецессивным типом наследования.
Прогноз благоприятный. Медикаментозного лечения не существует. Общие рекомендации — см. синдром Жильбера.
Содержание файла Функциональная гипербилирубинемия
• Синдромы Криглера-Найяра, Дубина-Джонсона, Ротора.
Источники
Дата создания файла: 4 апреля 2009 г.
Документ изменён: 4 апреля 2009 г.
Copyright © Ванюков Д.А.
![]() |
содержание файла
Функциональная гипербилирубинемия (пигментный гепатоз)
Синдром Жильбера— Леребулле - семейная гипербилирубинемия. Синдром Криглера — Найяра и Люцея — Ариаса — Дрисколла
Синдром Жильбера— Леребулле - семейная гипербилирубинемия. Синдром Криглера — Найяра и Люцея — Ариаса — Дрисколла
Синдром Жильбера— Леребулле, семейная гипербилирубинемия, связан с нарушением функции ферментов, обеспечивающих перенос непрямого билирубина из крови в печеночную клетку. Очевидно, происходит в какой-то степени и снижение процессов конъюнгации билирубина. Врожденное заболевание с аутосомно-доминантным типом наследования. Чаще болеют мальчики или взрослые мужчины, выявление болезни в периоде новорожденности маловероятно. Морфологические изменения в печени либо отсутствуют (у 0,25 больных), либо носят неспецифический характер.
Находят отложение липофусцина или жировую дистрофию гепатоцитов. Звездчатые эндотелиоциты образуют небольшие скопления.
При электронно-микроскопическом исследовании обнаруживается уменьшение числа и деформация микроворсинок на синусоидальном полюсе гепатоцитов.
Синдром Криглера — Найяра — тяжелое заболевание, связанное с врожденным отсутствием ферментов, участвующих в конъюгации билирубина. Наследуется аутосомно-рецессивно, встречается редко. Выявляется заболевание в периоде иоворожденности тяжелой желтухой, связанной с высоким (684 мкмоль/л — 40 мг% и более) содержанием непрямого билирубина.
Небольшое количество его выделяется железами кишечника, в связи с чем кал окрашен в бледно-желтый цвет. Обычно развивается смертельная билирубиновая энцефалопатия. Описаны единичные случаи, когда больные, несмотря на желтуху доживают до зрелого возраста.
Некоторые данные и, в частности, наличие обоих заболеваний в одних и тех же семьях свидетельствуют о близости синдромов Жильбера — Леребулле и Криглера — Найяра. Последний, по-видимому, является крайним вариантом первого.
Печень несколько увеличена лишь в редких случаях. Микроскопически выявляются желчные «тромбы» в канальцах, у части больных небольшой перипортальный фиброз или значительная жировая дистрофия гепатоцитов. При электронно-микроскопическом исследовании обнаруживается повреждение мембраны гепатоцита на синусоидальном полюсе с уменьшением числа микроворсинок и выходом органелл в перикатшллярные пространства (Диссе). Имеется также гиперплазия цитоплазматической сети, отложение желчного пигмента в гепатоцитах и эндотелиоцитах. Липофусцин в гепатоцитах не содержится.
Изменения мозга заключаются в ядерной желтухе с окрашивании гиппокамповой извилины, ядер ствола мозга и мозжечка. Имеются также очаги некроза в миокарде и скелетных мышцах, эрозии слизистой оболочки желудка и кишечника.
Преходящая семейная желтуха Люцея — Ариаса—Дрисколла, обменные или лекарственные гипербилирубинемии, проявляются в периоде иоворожденности (иногда на 7—9-е сутки) интенсивной желтухой с наличием в крови непрямого билирубина.
Нарушение конъюгации билирубина происходит при синдроме Люцея — Ариаса — Дрисколла в результате того, что на ферментные системы связывания билирубина Действует ингибитор, проникающий через плаценту от беременной женщины и являющийся, очевидно, прогестероном.
Аналогичное действие вызывают стероиды, в частности 3-а-20-бета-прегнандиол вырабатываемые в организме некоторых родильниц и поступающие в организм новорожденного с молоком. Прекращение кормления ребенка молоком матери ведет в этих случаях к быстрой нормализации билирубина, но возможно и тяжелое течение с развитием билирубиновой энцефалопатии. Как и при других желтухах, связанных с нарушением конъюгации билирубина, при синдроме Люцея — Ариаса — Дрисколла отсутствуют признаки гемолиза и грубые поражения печели. Отсутствует и плейохромия (интенсивная окраска) желчи и кала.
Ранняя желтуха новорожденного может быть также обусловлена поступлением через плаценту во время родов из организма беременной женщины эстрогенов, метаболитов, тормонов надпочечников и др. Связывание этих веществ происходит так же, как и непрямого билирубина. Перегрузка ферментных систем приводит к задержке выделения билирубина.
После рождения аналогичное конкурентное действие могут оказать многие лекарственные вещества (барбитураты, салицилаты, сульфаниламиды и др.).
Для конъюгации билирубина необходима глюкоза (в виде уридиндифосфатглюкозы), поэтому состояния, сопровождающиеся дефицитом глюкозы в организме новорожденного и гипогликемией, могут осложниться задержкой непрямого билирубина.
Синдром Жильбера— Леребулле - семейная гипербилирубинемия. Синдром Криглера — Найяра и Люцея — Ариаса — Дриско

Синдром Жильбера— Леребулле - семейная гипербилирубинемия. Синдром Криглера — Найяра и Люцея — Ариаса — Дрисколла
Синдром Жильбера— Леребулле, семейная гипербилирубинемия, связан с нарушением функции ферментов, обеспечивающих перенос непрямого билирубина из крови в печеночную клетку. Очевидно, происходит в какой-то степени и снижение процессов конъюнгации билирубина. Врожденное заболевание с аутосомно-доминантным типом наследования. Чаще болеют мальчики или взрослые мужчины, выявление болезни в периоде новорожденности маловероятно. Морфологические изменения в печени либо отсутствуют (у 0,25 больных), либо носят неспецифический характер.
Находят отложение липофусцина или жировую дистрофию гепатоцитов. Звездчатые эндотелиоциты образуют небольшие скопления.
При электронно-микроскопическом исследовании обнаруживается уменьшение числа и деформация микроворсинок на синусоидальном полюсе гепатоцитов.
Синдром Криглера — Найяра — тяжелое заболевание, связанное с врожденным отсутствием ферментов, участвующих в конъюгации билирубина. Наследуется аутосомно-рецессивно, встречается редко. Выявляется заболевание в периоде иоворожденности тяжелой желтухой, связанной с высоким (684 мкмоль/л — 40 мг% и более) содержанием непрямого билирубина.
Небольшое количество его выделяется железами кишечника, в связи с чем кал окрашен в бледно-желтый цвет. Обычно развивается смертельная билирубиновая энцефалопатия. Описаны единичные случаи, когда больные, несмотря на желтуху доживают до зрелого возраста.
Некоторые данные и, в частности, наличие обоих заболеваний в одних и тех же семьях свидетельствуют о близости синдромов Жильбера — Леребулле и Криглера — Найяра. Последний, по-видимому, является крайним вариантом первого.

Печень несколько увеличена лишь в редких случаях. Микроскопически выявляются желчные «тромбы» в канальцах, у части больных небольшой перипортальный фиброз или значительная жировая дистрофия гепатоцитов. При электронно-микроскопическом исследовании обнаруживается повреждение мембраны гепатоцита на синусоидальном полюсе с уменьшением числа микроворсинок и выходом органелл в перикатшллярные пространства (Диссе). Имеется также гиперплазия цитоплазматической сети, отложение желчного пигмента в гепатоцитах и эндотелиоцитах. Липофусцин в гепатоцитах не содержится.
Изменения мозга заключаются в ядерной желтухе с окрашивании гиппокамповой извилины, ядер ствола мозга и мозжечка. Имеются также очаги некроза в миокарде и скелетных мышцах, эрозии слизистой оболочки желудка и кишечника.
Преходящая семейная желтуха Люцея — Ариаса—Дрисколла, обменные или лекарственные гипербилирубинемии, проявляются в периоде иоворожденности (иногда на 7—9-е сутки) интенсивной желтухой с наличием в крови непрямого билирубина.
Нарушение конъюгации билирубина происходит при синдроме Люцея — Ариаса — Дрисколла в результате того, что на ферментные системы связывания билирубина Действует ингибитор, проникающий через плаценту от беременной женщины и являющийся, очевидно, прогестероном.
Аналогичное действие вызывают стероиды, в частности 3-а-20-бета-прегнандиол вырабатываемые в организме некоторых родильниц и поступающие в организм новорожденного с молоком. Прекращение кормления ребенка молоком матери ведет в этих случаях к быстрой нормализации билирубина, но возможно и тяжелое течение с развитием билирубиновой энцефалопатии. Как и при других желтухах, связанных с нарушением конъюгации билирубина, при синдроме Люцея — Ариаса — Дрисколла отсутствуют признаки гемолиза и грубые поражения печели. Отсутствует и плейохромия (интенсивная окраска) желчи и кала.
Ранняя желтуха новорожденного может быть также обусловлена поступлением через плаценту во время родов из организма беременной женщины эстрогенов, метаболитов, тормонов надпочечников и др. Связывание этих веществ происходит так же, как и непрямого билирубина. Перегрузка ферментных систем приводит к задержке выделения билирубина.
После рождения аналогичное конкурентное действие могут оказать многие лекарственные вещества (барбитураты, салицилаты, сульфаниламиды и др.).
Для конъюгации билирубина необходима глюкоза (в виде уридиндифосфатглюкозы), поэтому состояния, сопровождающиеся дефицитом глюкозы в организме новорожденного и гипогликемией, могут осложниться задержкой непрямого билирубина.
- Читать далее "Физиологическая желтуха новорожденных. Синдромы Дабина — Джонсона и Ротора"
Оглавление темы "Врожденные формы желтухи у новорожденных":
1. Послеродовая желтушная форма гемолитической болезни. Анемическая форма гемолитической болезни
2. Плацента при гемолитической болезни. Билирубиновая энцефалопатия
3. Ядерная желтуха. Признаки ядерной желтухи у плода
4. Послежелтушная энцефалопатия. Наследственный микросфероцитоз - болезнь Минковского-Шоффара
5. Наследственный стоматоцитоз. Дефицит глюкозо-6-фосфатдегидрогеназы плода
6. Дефицит пируваткиназы у плода. Гемоглобинозы
7. Гемоглобиноз S. Талассемия у новорожденных
8. Классификация желтух новорожденных. Синдром Израельса
9. Синдром Жильбера— Леребулле - семейная гипербилирубинемия. Синдром Криглера — Найяра и Люцея — Ариаса — Дрисколла
10. Физиологическая желтуха новорожденных. Синдромы Дабина — Джонсона и Ротора
Врожденные метаболические нарушения, вызывающие гипербилирубинемию
Синдром Криглера-Найяра
Это редкое наследственное заболевание печени вызвано дефицитом фермента глюкуронилтрансферазы (UGT1A1), который катализирует конъюгацию билирубина (главным образом в билирубина диглюкуронид), что делает билирубин растворимым в воде. Различные дефекты в гене, кодирующем фермент, вызывают полную (тип 1) или частичную (тип 2) инактивацию фермента.
Пациенты с аутосомно-рецессивным типом II (partial) данного заболевания (которое имеет вариабельную пенетрантность) часто имеют менее выраженную неконъюгированную гипербилирубинемию ( 20 мг/дл [ 342 мкмол/л]) и обычно доживают до зрелого возраста без неврологических нарушений. Фенобарбитал в дозе 1,5–2 мг/кг перорально 3 раза/день, индуцируя активность глюкуронилтрансферазы в условиях ее частичного дефицита, может быть эффективным методом лечения.
Синдром Дабина-Джонсона и синдром Ротора
Синдром Дабина – Джонсона и синдром Ротора вызывают конъюгированную гипербилирубинемию, но без признаков холестаза, не имеют других симптомов или последствий, кроме желтухи. В моче может определяться билирубин в отличие от неконъюгированной желтухи при синдроме Жильбера Синдром Жильбера Наследственные или врожденные заболевания могут вызывать неконъюгированную или конъюгированную гипербилирубинемию (см. Обзор метаболизма билирубина). Неконъюгированная гипербилирубинемия: синдром. Прочитайте дополнительные сведения (также не вызывающем других симптомов), при котором билирубин в моче отсутствует. Уровень аминотрансферазы и щелочной фосфатазы обычно нормальный. Лечение не требуется.
Синдром Дубина-Джонсона
Редкое аутосомно-рецессивное заболевание, связанное с нарушенным выведением связанного билирубина. Обычно диагноз ставится на основании биопсии печени Биопсия печени Биопсия печени предоставляет информацию о структуре печени и характере ее повреждения (тип и степень, наличие фиброза); эта информация может быть необходима не только для диагноза, но также. Прочитайте дополнительные сведения ; печень сильно пигментирована в результате наличия внутриклеточного меланиноподобного пигмента, но в целом остается гистологически нормальной.
Синдром Ротора
Это редкое заболевание, клинически схожее с синдромом Дабина – Джонсона, но печень не пигментирована и присутствуют другие метаболические изменения.
Синдром Жильбера
Синдром Жильбера – врожденное нарушение обмена билирубина, протекающее, как правило, бессимптомно, проявляющееся умеренной неконъюгированной гипербилирубинемией. Ошибочно может быть принят за хронический гепатит или другое заболевание печени.
Синдром Жильбера может поражать до 5% людей. Хотя это нарушение и может наблюдаться у членов семьи, генетическую закономерность определить тяжело.
Патогенез может включать сложные дефекты переработки билирубина в печени. Активность глюкуронилтрансферазы снижена, хотя и не настолько сильно, как при синдроме Криглера – Найяра Синдром Криглера-Найяра Наследственные или врожденные заболевания могут вызывать неконъюгированную или конъюгированную гипербилирубинемию (см. Обзор метаболизма билирубина). Неконъюгированная гипербилирубинемия: синдром. Прочитайте дополнительные сведения типа II. У многих пациентов также несколько усилено разрушение эритроцитов, но это не вызывает анемию или гипербилирубинемию. Гистология печени нормальная.
Синдром Жильбера чаще всего выявляется случайно у молодых людей при обнаружении повышенного уровня билирубина, который обычно колеблется от 2 до 5 мг/дл (34 и 86 мкмоль/л) и имеет тенденцию повышаться при голодании и различных стрессах.
Синдром Жильбера дифференцируют с гепатитом по фракциям билирубина, что показывает преобладание неконъюгированной формы, а также нормальным печеночным тестам и отсутствию билирубина в моче. Отличие от гемолиза заключается в отсутствии анемии и ретикулоцитоза.
Лечение не требуется. Пациентов необходимо убеждать в том, что у них нет заболевания печени.
Первичная шунтовая гипербилирубинемия
Это редкое семейное доброкачественное состояние характеризуется избыточным синтезом раннего билирубина (билирубина, полученного в результате неэффективного эритропоэза и из негемоглобинового гема, а не в результате нормального оборота эритроцитов).
Авторское право © 2022 Merck & Co., Inc., Rahway, NJ, США и ее аффилированные лица. Все права сохранены.
Cемейные формы функциональных гипербилирубинемий в работе практического врача
Ребенок с синдромом Криглера — Найяра I типа Пациенты с функциональными гипербилирубинемическими состояниями длительное время (по нашим данным, от 6 месяцев до 3 лет и более) наблюдаются с первоначально ошибочными диагнозами. Таблица
![]() |
| Ребенок с синдромом Криглера — Найяра I типа |
Пациенты с функциональными гипербилирубинемическими состояниями длительное время (по нашим данным, от 6 месяцев до 3 лет и более) наблюдаются с первоначально ошибочными диагнозами.
Известно, что синдром желтух у детей представлен массой состояний. И если гемолитические, гепатитные и, реже встречающие в детском возрасте, механические (хирургические = подпеченочные) желтухи хорошо известны педиатрам и учитываются в дифференциальной диагностике, то так называемые семейные формы (функциональные гипербилирубинемические синдромы) чаще описываются в разделе казуистики [3, 4]. Но по мере изменения структуры заболеваемости на первый план выдвигаются наследственные синдромы. Пациенты с функциональными гипербилирубинемическими состояниями, прежде всего дети, длительное время (по нашим данным, от 6 мес. до 3 лет и более) наблюдаются с первоначально ошибочными диагнозами (гепатиты и т. п.). Между тем вспомнить о заболевании — это значит на 50% его диагностировать.
В связи с этим мы решили обобщить данные литературы и результаты собственных наблюдений.
По времени манифестации и тяжести проявлений одно из первых мест занимает синдром Криглера — Найяра [1].
Синдром Криглера — Найяра тип I — врожденная семейная негемолитическая желтуха с ядерной желтухой в результате полного отсутствия уридин-дифосфат-глюкоронилтрансферазы (УДФГТ) при нормальных функциях печени и отсутствии признаков гемолиза или резус-конфликта.
Патогенез заболевания заключается в отсутствии или резком снижении активности УДФГТ [6], в результате чего значительно повышается сывороточный уровень неконъюгированного жирорастворимого билирубина. Он связывается с альбумином, диффундирует через плацентарный и гематоэнцефалический барьеры (последнее — только у новорожденных). Связывающая (своеобразная буферная, компенсаторная емкость) альбумина уменьшается и соответственно клиническое течение синдрома ухудшается при гипоальбуминемии, ацидозе, увеличении концентрации органических ионов, назначении гепарина, салицилатов, сульфаниламидов, употреблении свободных жирных кислот. Проникновение несвязанного, неконъюгированного билирубина в клетки и митохондрии ведет к блокаде окислительно-фосфорилирующих реакций, особенно в гипоталамусе, хвостатом ядре, подкорковых ядрах, мозжечке.
| По частоте среди врожденных функциональных билирубинемий на первом месте стоит синдром Жильбера. Наш опыт работы в многопрофильных педиатрической и терапевтической клиниках показал, что в каждой из них за год выявляется порядка 10—20 случаев синдрома. |
Клинически отмечается желтуха. Неконъюгированный билирубин может достигать концентрации 400 —450 мг/л. Фекальный уробилиноген не превышает 100 мг/л. Ядерная желтуха проявляется билирубиновой энцефалопатией в виде гипотонии, летаргии, а также резким угнетением или даже отсутствием сосательного рефлекса, неврогенной и метаболической гипотрофией, опистотонусом, спастикой. Применение фенобарбитала или глутетемида — индукторов микросомальных ферментов — не дают положительных результатаов. Функциональные пробы печени (выделение индоцианина зеленого, бромсульфталеина), а также холангиография, гистология печени и гематологические находки не добавляют ничего существенного к общей клинической картине. Прогноз заболевания очень плохой, больные редко живут больше 18 мес.
Дифференциальная диагностика (ДД) проводится с синдромами Жильбера — Мойленграхта, Дабина — Джонса, Ротора, Люси — Дрисколла, ядерной желтухой новорожденных любой другой этиологии, врожденными циррозами печени и гепатитами, атрезией желчных ходов или тонкого кишечника (см. табл.).
Значительно благоприятней протекает синдром Криглера — Найяра типа II. Определение его [7] почти в точности повторяет синдром Криглера — Найяра типа I (врожденная семейная негемолитическая желтуха с ядерной желтухой при нормальных функциях печени), с той лишь разницей, что УДФГТ присутствует, хотя активность фермента значительно снижена. Уровень неконъюгированного билирубина может колебаться в пределах 60— 250 мг/л, фекального уробилиногена — 200—800 мг/л. Эффект от применения фототерапии и индукторов микросомальных ферментов хороший. Желтуха редко достигает степени ядерной, больные доживают до 50 и более лет, но в отделенном периоде, особенно при запоздалом лечении, нередки случаи глухоты, хореоатетоза, нейромышечных и личностых отклонений, гипоплазии зубов.
По частоте среди врожденных семейных функциональных билирубинемий на 1-м месте стоит синдром Жильбера. Наш опыт работы в многопрофильных — педиатрической и терапевтической — клиниках показал, что в каждой из них за год выявляется порядка 10 — 20 случаев синдрома. Но истинная частота, видимо, выше, поскольку диагностика заболевания строится главным образом на данных клиники и функциональной пробы с голоданием, а «клиническая мягкость» не привлекает внимание врача. Так, С. Д. Подымова [5] считает, что синдром Жильбера имеют не менее 1— 5% населения. Наблюдая таких больных, мы пришли к заключению, что синдром ассоциируется с генерализованной дисплазией соединительной ткани (особенно часто по типу синдромов Марфана и Элерса — Данлоса).
Патогенез синдрома неоднозначный. Обнаруживается небольшое снижение активности УДФГТ (на 10 — 30% по сравнению с нормой), однако основное значение придается нарушению захвата билирубина гепатоцитами. Последнее связывают с аномалией проницаемости мембран и с дефектом белка внутриклеточного транспорта. Эта гетерогенность клиренса билирубина проявляется также вариабельностью таких тест-субстратов, как бромсульфталеин и индоцианин зеленый.
Клинически для синдрома характерна субиктеричность различной степени выраженности. Чаще это выражается в иктеричности склер, матовой желтушности кожи, особенно лица, иногда частичном пожелтении стоп и ладоней, подмышечных впадин и носогубного треугольника. Нередко больные жалуются на общую слабость, подавленность, плохой сон, трудность концентрации внимания. Влияние голода на повышение содержания билирубина в сыворотке известно и для здоровых, но значительно выражено при синдроме Жильбера. С целью его выявления проводят пробу с голоданием. В течении 48 часов больной получает питание энергетической ценностью 400 ккал/сутки. В день начала пробы утром натощак и спустя 2 суток определяют билирубин сыворотки крови. При подъеме его на 50 — 100% проба считается положительной.
В последнее время многие специалисты полностью идентифицируют его с синдромом Мойленграхта, рассматривая их как одно состояние — синдром Жильбера — Мойленграхта — и определяют его как доброкачественную семейную конституциональную гибербилирубинемию в результате аномалии ферментов печени [7]. Большое значение для диагноза имеет семейный анамнез (легкая желтушность у членов семьи больного). Клиническая картина проявляется интермиттирующей мало выраженной желтухой, никогда не сопровождающейся ядерной. Желтуха усиливается при голодании, о чем говорилось выше, физических перегрузках, оперативных вмешательствах, употреблении алкоголя, инфекционных заболеваниях. Больных беспокоят тошнота, чувство переполнения желудка, тяжесть в эпигастрии, боли в правом подреберье, запоры или диспепсии. Почти у половины больных обнаруживается скрытый гемолиз (группа риска по холелитиазу!). Наряду с уже упомянутыми неврологическими расстройствами в рамках общей дисплазии соединительной ткани, свойственной этим больным, описывают и такие проявления, как пылающие и пигментные невусы, пигментация век, брадикардия и артериальная гипотония. Применение индукторов микросомальных ферментов очень эффективно. Прогноз хороший. Диагноз строится на клиническом исследовании и лабораторно-функциональных пробах. Гистологические находки (см. табл.) неспецифичны и обнаруживаются далеко не всегда. Поэтому ввиду общего нетяжелого состояния пациентов пункционная биопсия печени вряд ли оправданна (напомним, что риск обследования не должен превышать риска неустановленного диагноза и что прежде больные погибали от болезни, позже от лечения, а сейчас — от обследования).
ДД проводится со всеми типами неконъюгированной билирубинемии, синдромом Криглера — Найяра типа II, гемолитическими анемиями, шунтовыми гипербилирубинемиями (неэффективный гемопоэз с интрамедуллярным образованием значительного количества билирубина = талассемия, пернициозная анемия), постгепатической персистирующей гипербилирубинемией.
Синдром Дабина — Джонса — семейное нарушение выведения конъюгированного билирубина в желчные ходы, сочетающееся с отложением пигмента в печеночных клетках и умеренным увеличением печени («шоколадная печень»). При нем отсутствует нарушение глюкоронирования. Патогенез заключается в недостаточности транспорта конъюгированного билирубина внутрь и из гепатоцита. Билирубин попадает в кровь, его уровень в крови повышается, затем он усиленно выводится через почки. Заболевание может дебютировать в любом возрасте (разная пенетрантность гена?), но нередко проявляется после приема гормональных противозачаточных препаратов или при беременности.
| Влияние голода на повышение содержания билирубина в сыворотке известно и для здоровых людей, но значительно выражено при синдроме Жильбера. С целью его выявления проводят пробу с голоданием. В течение 48 часов больной получает питание энергетической ценностью 400 ккал/сутки. В первый день пробы натощак и спустя двое суток определяют билирубин сыворотки крови. При подъеме его на 50 — 100% проба считается положительной. |
Клинически ВВ проявляется в рецидивирующих периодах желтухи разной степени выраженности, но, как правило, не сопровождается зудом; увеличение размеров печени, а затем и селезенки умеренное. Функциональные печеночные пробы не изменены или изменены незначительно, однако наблюдается замедленное выведение контраста в желчный пузырь, повышение уровня копропорфирина I и снижение уровня копропорфирина III в моче. Гистологически в рибосомах печени откладывается меланиноподобный пигмент от желто-коричневого до черного цвета. Купферовские клетки остаются свободными, а соединительная ткань не разрастается.
Формой синдрома Дабина — Джонса (или самостоятельной нозологической единицей?) является синдром Бюрка. При этом также обнаруживается липохромный гепатоз, но БЕЗ желтухи, хотя и СО ЗНАЧИТЕЛЬНОЙ гепатоспленомегалией.
Синдром Ротора — идиопатическая семейная доброкачественная гипербилирубинемия с адекватным повышением конъюгированного и неконъюгированного билирубина.
Патогенез заключается в нарушенном захвате неконъюгированного билирубина гепатоцитами, изменении его глюкоронирования и выведении с последующим рефлюксом билирубина в кровь.
Клинически синдром проявляется хронической желтухой (или субиктеричностью) кожи и слизистых. При этом ее интенсивность флюктуирует, увеличения размеров печени и селезенки не наблюдается. Гистологическая картина печени при световой микроскопии не изменена, при электронной микроскопии — митохондрии различных размеров, в фаголизосомах — пигментные тельца в виде решетчатообразных включений [8].
Диагнозы постгепатической доброкачественной гипербилирубинемии и физиологической желтухи новорожденных, постпрандиальных желтух (длительное употребление большого количества тугоплавких жиров), как прогностически благоприятные, строятся на принципе исключения более тяжелых вариантов гипербилирубинемий. Можно предположить, что подобные состояния связаны с маломанифестными ферментными аномалиями или аномалиями развития желчного пузыря (перетяжки, перегибы, особенно — в области сифона, сужения холедоха, приводящие к повышению давления в желчных ходах и избыточной нагрузке на гепатоцит).
| Синдром Дабина — Джонса может дебютировать в любом возрасте (разная пенетрантность гена?), но нередко проявляется после приема гормональных противозачаточных препаратов и при беременности. |
Семейный доброкачественный возвратный холестаз = синдром Аагенеса = Саммерскилла-Тигструппа = норвежский холестаз = холестаз с лимфедемами. Само обилие синонимов говорит о редкости синдрома: каждый вновь описываемый случай представляется авторам как открытие. Поскольку он редко встречается в литературе, определить истинную его распространенность весьма сложно. В основном он известен из описаний скандинавских авторов. Вероятно, патогенез заключается в гипоплазии лимфатических сосудов печени и других органов.
Клинически синдром проявляется как холестаз (наиболее чувствительный и специфический фермент холестаза — лейцин-аминопептидаза) уже в неонатальном периоде. Затем холестаз самостоятельно уменьшается, рецидивируя у взрослых. Медленно развиваются лимфатические отеки. Типичны гепатомегалия и нарушение функций печени. Гистологически он выражен внутрипеченочным холестазом с гигантоклеточной трансформацией.
Хронический холестаз сопровождается дефицитом жирорастворимых витаминов. Дефицит витамина Е приводит к прогрессирующей мозжечково-спинальной дегенерации (синдром Пермуттера).
ДД синдрома Аагенеса проводится со всеми синдромами холестаза и врожденных лимфатических отеков (синдромы Милроя, Вевера — Смита).
Злокачественный семейный холестаз (болезнь Байлера = синдром Клейтон — Юберга). В подавляющем большинстве случаев проявляется на 1-м году жизни [1]. Вначале холестаз (желтуха) самостоятельно разрешается через несколько недель или месяцев. Затем интенсивность желтухи нарастает, присоединяется мучительный зуд. Печень и селезенка существенно увеличиваются. В результате поражения паренхимы печени возникает геморрагический синдром. Эхографически печень выглядит плотной, напоминает цирротическую, в просвете желчного пузыря наблюдается густой застой. Прогноз плохой.
ДД проводят со всеми синдромами холестаза и синдромом Алажиль.
Синдром Люси — Дрисколл — аутосомно-рециссивно наследуемое редкое состояние, проявляющееся массивной гипербилирубинемией, развивающейся у всех детей, рожденных от одной матери страдающей этим заболеванием, в первые четыре дня их жизни.
Патогенез заключается в наличии фактора — ингибитора конъюгации билирубина в крови и моче матери и постнатально в крови и моче детей. Сыворотка таких матерей ингибирует in vitro конъюгацию билирубина в 5 — 7 раз сильнее, чем сыворотка женщин, не являющихся кондукторами данного синдрома. Вероятно, подобный фактор представлен стероидом, но он до сих пор не идентифицирован. Клиническая картина соответствует тяжелой гипербилирубинемии вплоть до ядерной желтухи.
ДД проводится с синдромами Криглера — Найяра типов I и II, новобиоциновой желтухой, эстрогеновой (транзиторная желтуха детей, вскармливаемых грудным молоком) и окситоциновой желтухой.
Лечение семейных функциональных гипербилирубинемий проводится по следующим принципам:
- выведение конъюгированного билирубина (усиленный диурез, активированный уголь как адсорбент билирубина в кишечнике);
- связывание уже циркулирующего билирубина в крови (введение альбумина в дозе 1 г/кг массы в течение 1 часа). Особенно целесообразно введение альбумина перед заменным переливанием крови;
- разрушение билирубина, фиксированного в тканях, тем самым освобождаются рецепторы, периферические рецепторы, которые могут связать новые порции билирубина, предотвращается его проникновение через гематоэнцефалический барьер. Достигается это посредством фототерапии. Максимальный эффект наблюдается при длине волны 450 нм. Лампы с синим светом более эффективны, однако они затрудняют наблюдение за кожей ребенка. Фотоисточник помещают на расстоянии 40 — 45 см над телом (процедуру проводить только в кювезе при контроле температуры). Глаза ребенка необходимо защитить. Фотодеградацию билирубина усиливает рибофлавин, являющийся даже во внутриклеточной концентрации хромофором. Необходимая длительность фототерапии уменьшается и при добавлении холестирамина, хотя этот препарат менее физиологичен, чем рибофлавин. Фототерапия значительно эффективней при одновременном проведении сеансов оксигенобаротерапии [8], так как кислород усиливает декомпозицию билирубина;
- при синдромах, обусловленных снижением активности УДФГТ (например, Криглера — Найяра тип 11), назначение индукторов микросомальных ферментов: фенобарбитал до 5 мг/кг сутки, а после 12 лет и глутетимид. Перспективным видится применение цитохромов;
- стремление избежать провоцирующих факторов (инфекции, перегрузки), препаратов — конкурентов глюкоронирования или вытесняющих билирубин из связи с альбумином (пероральные контрацептивы, сульфаниламиды, гепарин, салицилаты). Следует избегать состояний, сопровождающихся повышенной проницаемостью гематоэнцефалического барьера (ацидоз);
- использование достаточной водной нагрузки (профилактика синдрома сгущения желчи);
- при наличии плазменных ингибиторов глюкуронирования, передающихся с молоком матери, прогревание молока при 56°С в течение 15 мин;
- применение дополнительных доз жирорастворимых витаминов, микроэлементов;
- в критических случаях — обменное переливание крови.
Литература
1. Алажиль Д., Одъевр М. Заболевания печени и желчных путей у детей. М.: Медицина, 1982. — 486 с.
2. Асоян А. В. Применение гипербарической оксигенации в комплексном лечении гипербилирубинемии у новорожденных с гемолитической болезнью. Автореф. дис. к. м. н. М., 1985. — 24 с.
3. Гасан Абу-Джабаль. Хронический гастродуоденит у детей на фоне дисплазии соединительной ткани. Автореф. дис. к. м. н. М., 1997. — 24 с.
4. Имамбаев С.Е. Эхография в диагностике заболеваний желчевыводящей системы у детей. Автореф. дис. к. м. н. М., 1986. — 24 с.
5. Подымова С. Д. Болезни печени. М.: Медицина, 1993. — 544 с.
6. Emery A., Rimoin D. (Ed.) Principles and practice of medical Genetics. London, Vv. 1, 2. — 1983.
7. Leiber B. Die klinischen Syndrome. Muenchen. — 1990.
8. Moelbert E., Marx R. Elektronenmikroskopiesche Untersuchungen am Lebergewebe beim Rotor-Syndrom. Acta hepato-splenoloy, 1966. — 13. — ss. 160 — 175.
Читайте также: